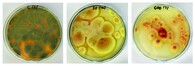
léky v půdě
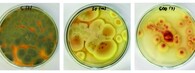
léky v půdě

reklama
reklama
fotobankaostatníPodgalerieFotografie |
Ekolist.cz je vydáván občanským sdružením BEZK. ISSN 1802-9019. Za webhosting a publikační systém TOOLKIT děkujeme Ecn studiu. Navštivte Ecomonitor.
Copyright © BEZK. Copyright © ČTK, TASR. Všechna práva vyhrazena. Publikování nebo šíření obsahu je bez předchozího souhlasu držitele autorských práv zakázáno.
Copyright © BEZK. Copyright © ČTK, TASR. Všechna práva vyhrazena. Publikování nebo šíření obsahu je bez předchozího souhlasu držitele autorských práv zakázáno.